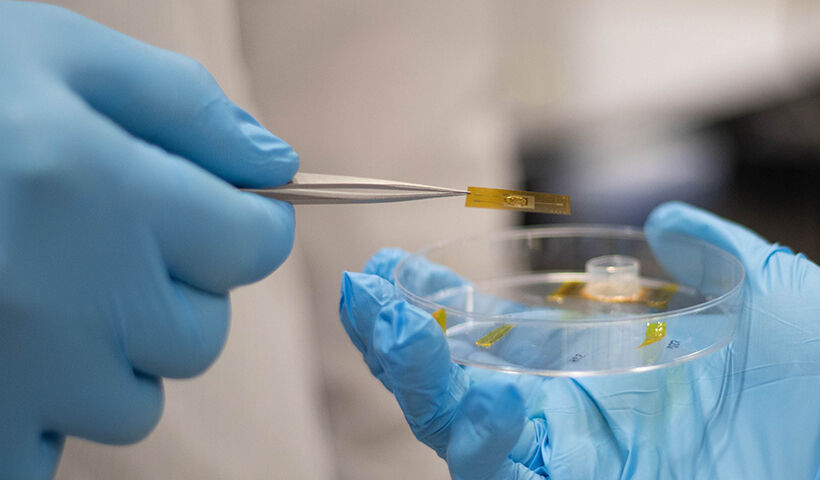

Elektro- und Informationstechnik
- Studienfeld(er): Elektrotechnik, Informationstechnik
- Startdatum: jährlich zum Wintersemester
- Regelstudienzeit: 6 Semester
- Studienform(en): Internationaler Studiengang, Teilzeitstudium, Vollzeitstudium, Praxisintegrierend
- Zulassungsmodus: Online-Aufnahmeprüfung zur Überprüfung der erforderlichen Vorkenntnisse in den Bereichen der Logik, der Mathematik und der naturwissenschaftlichen Fächer
- Trägerschaft: Ausländische Hochschulen
- Hauptunterrichtssprache: Deutsch
Das Studium im Portrait
Dieser dreisprachige Studiengang vereint Elektronik, Computer- und Automatisierungstechnik, bietet eine interdisziplinäre Ausbildung mit enger Verknüpfung von Theorie und Praxis und eröffnet Karrierechancen in den innovativsten Branchen.
Der Bachelor vermittelt die notwendigen Kompetenzen für die Entwicklung von elektronischen, eingebetteten und automatisierten Komponenten und Systemen und verbindet dabei eine fundierte theoretische Grundausbildung mit einem praxisorientierten Ansatz.
Absolvent:innen können in Schlüsselsektoren wie Informations- und Kommunikationstechnologien (IKT), Industrie 4.0, industrielle Automatisierung und in Bereichen mit Hightech-Anwendungen wie intelligente Landwirtschaft oder Robotik arbeiten, in denen fortgeschrittene Fähigkeiten in der Entwicklung von Elektronik- und Softwarelösungen erforderlich sind. Ihre Fähigkeiten bereiten sie auch auf Positionen in der Beratung, im technologischen Projektmanagement sowie in Forschung und Entwicklung vor, wo sie zur Lösung komplexer Herausforderungen in hochinnovativen Bereichen beitragen.
Universitätsplatz 1
39100 Bozen
Tel: 0039 0471 012100
Fax: 0039 0471 012109
E-Mail: apply@unibz.it
Sekundarschulabschluss oder gleichwertiger Titel
Die Unterrichtssprachen sind Deutsch, Englisch und Italienisch. Erforderliche Sprachkompetenzen:
1. Sprache: B2
2. Sprache: B1
3. Sprache: kein Niveau erforderlich
- Schwerpunkte:
- elektronische Bauelemente, analoge Elektronik, digitale Schaltungen und Systeme, Datenstrukturen und Algorithmen, moderne Steuerungen, Robotik, maschinelles Lernen, Industrie 4.0
- Weitere Sprachen:
- Englisch, Italienisch
1. Bewerbungssession: 03.03. - 06.05.2025
2. Bewerbungssession: 28.05. - 09.07.2025
Vorlesungszeit: Ende September - Mitte Juni
Bemerkung:
Anrecht auf Studienbeihilfe der Autonomen Provinz Bozen für alle EU-Bürger:innen- Zulassungssemester:
- jährlich zum Wintersemester
- Zulassungsmodus:
- Online-Aufnahmeprüfung zur Überprüfung der erforderlichen Vorkenntnisse in den Bereichen der Logik, der Mathematik und der naturwissenschaftlichen Fächer
- Zugangsvoraussetzungen:
Sekundarschulabschluss oder gleichwertiger Titel
Die Unterrichtssprachen sind Deutsch, Englisch und Italienisch. Erforderliche Sprachkompetenzen:
1. Sprache: B2
2. Sprache: B1
3. Sprache: kein Niveau erforderlich
- Schwerpunkte:
- elektronische Bauelemente, analoge Elektronik, digitale Schaltungen und Systeme, Datenstrukturen und Algorithmen, moderne Steuerungen, Robotik, maschinelles Lernen, Industrie 4.0
- Weitere Sprachen:
- Englisch, Italienisch
1. Bewerbungssession: 03.03. - 06.05.2025
2. Bewerbungssession: 28.05. - 09.07.2025
Vorlesungszeit: Ende September - Mitte Juni
- Studienbeitrag:
- 1200 € pro Jahr
- Studienbeitrag (Bemerkung):
- Anrecht auf Studienbeihilfe der Autonomen Provinz Bozen für alle EU-Bürger:innen
- Fakultät*:
- Fakultät für Ingenieurwesen
- Akkreditierung*:
- staatlich
Schlüsselbereiche
Es werden die drei Schlüsselbereiche Elektronik, Computer- und Automatisierungstechnik vermittelt, wobei die interdisziplinären Fähigkeiten vom Entwurf elektronischer Geräte und integrierter Schaltungen bis hin zur Realisierung automatisierter Systeme und Softwarelösungen reichen. Durch gezielte Lehrveranstaltungen und intensive praxisorientierte Lernmodule kann Wissen in verschiedensten Bereichen angewandt werden , z. B. in der intelligenten Landwirtschaft, der Medizintechnik, der Industrieautomatisierung und den Technologien des Internet of Things.